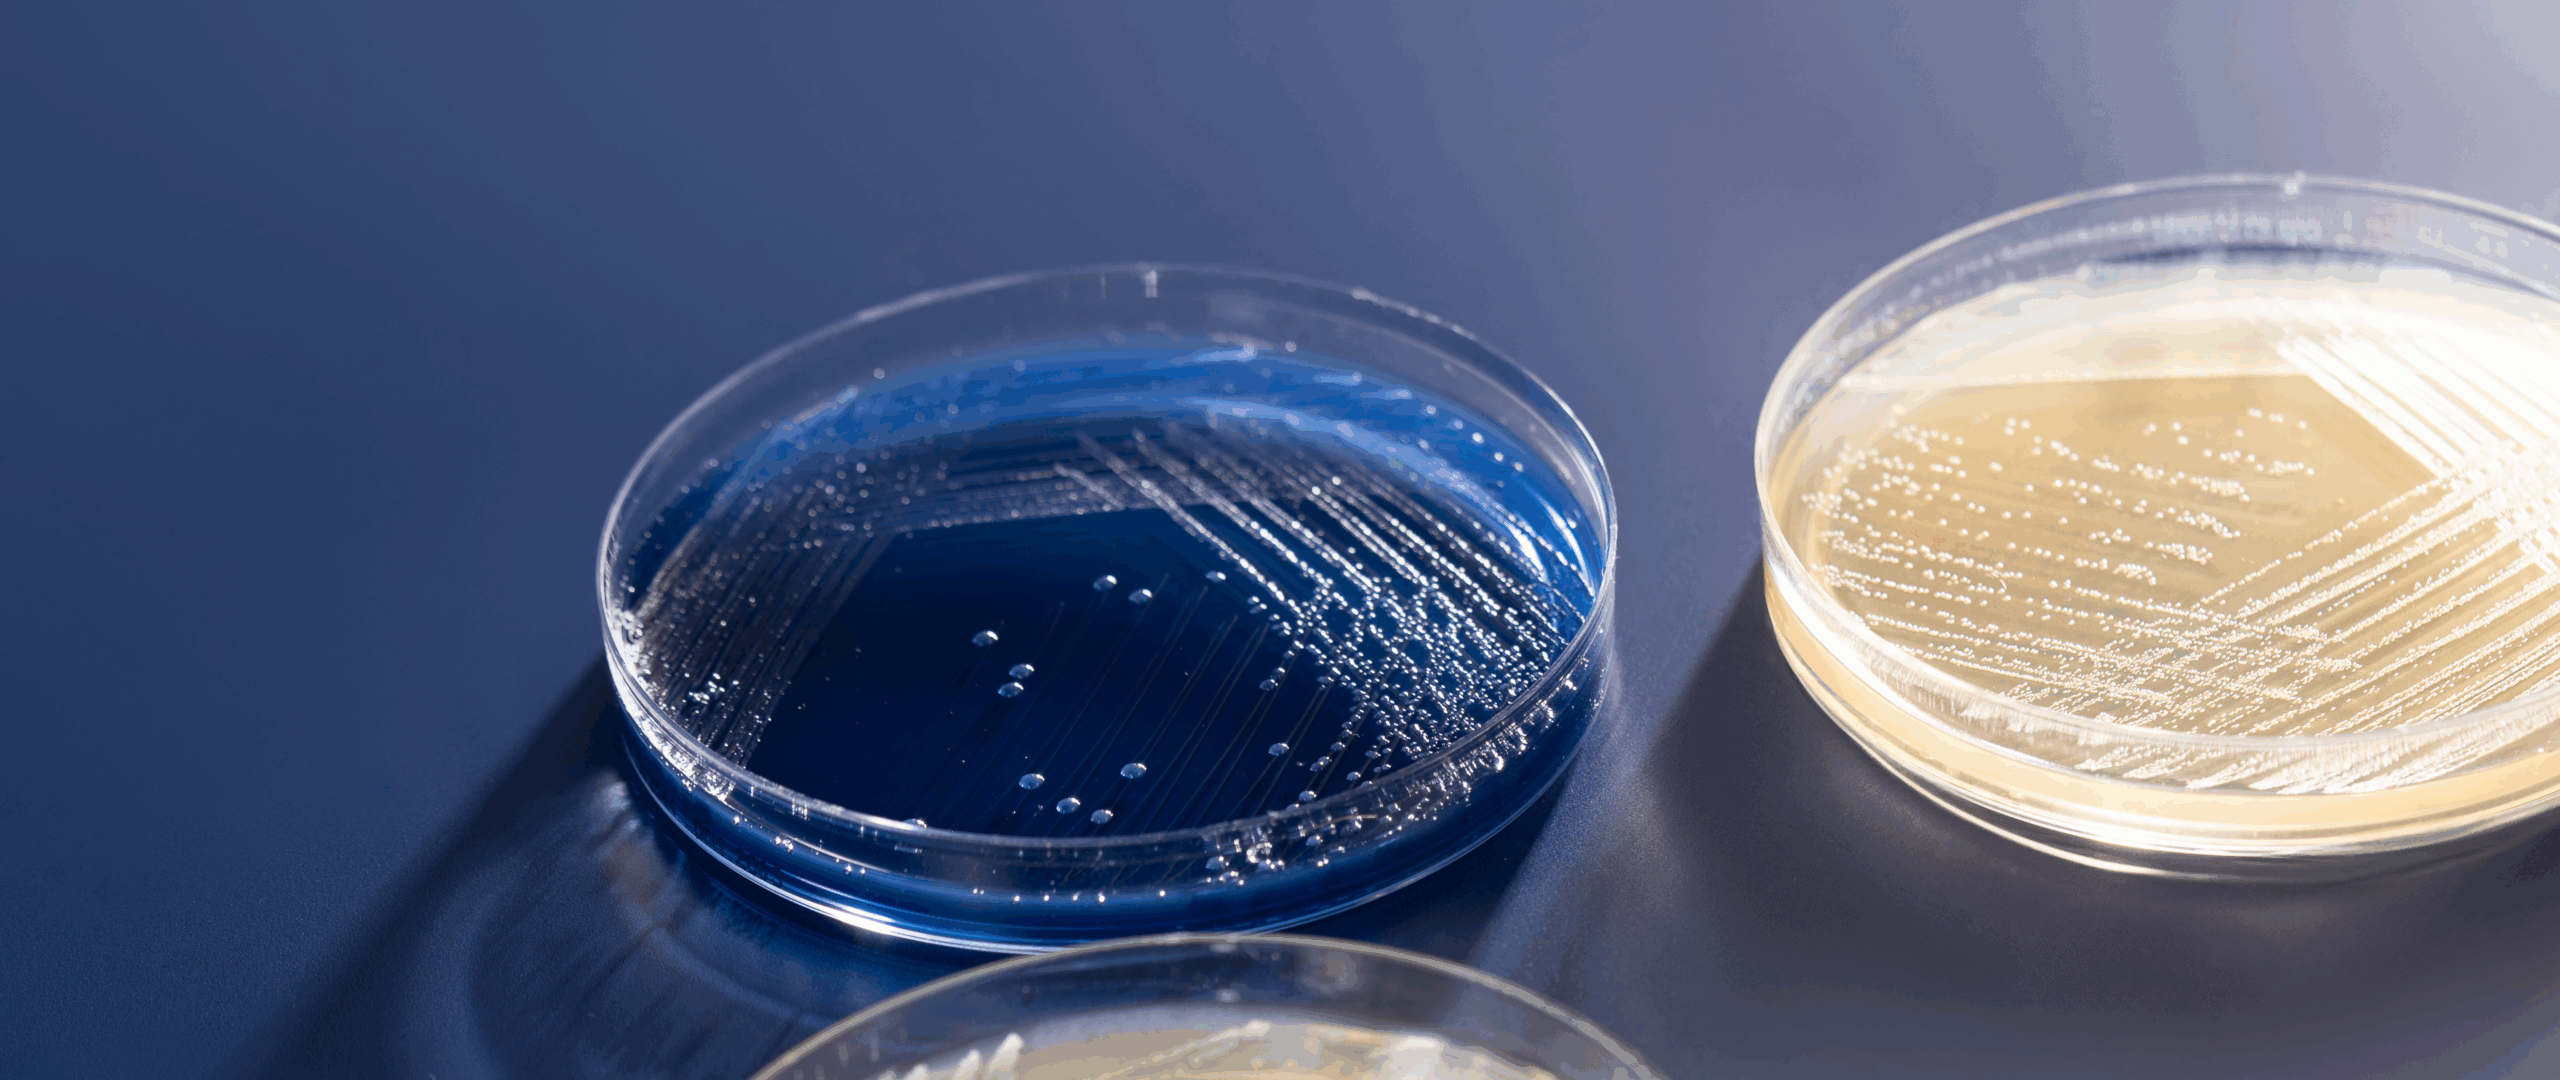

THIS WEBSITE IS FOR BUSINESS & INDUSTRY PARTNERS. FOR CONSUMER PRODUCTS VISIT : BLIS Probiotics >
THIS WEBSITE IS FOR BUSINESS & INDUSTRY PARTNERS. FOR CONSUMER PRODUCTS VISIT : BLIS Probiotics >
Elevate your product portfolio to new heights with differentiated and premium probiotics. These strains have been clinically proven to enhance health in multiple areas such as immunity, dental health, and ear, nose and throat health.

Global Key Account Manager ENQUIRE NOW
BLIS K12™ and BLIS M18™ are the world’s most proven strains for oral health, with over 110 peer reviewed publications. For those looking to add an efficacious ingredient for your own finished goods, we offer freeze-dried bulk probiotic powder.
Throughout the manufacturing process, we conduct repeated, rigorous testing and analysis every step of the way to guarantee the quality, purity, and safety of each strain.